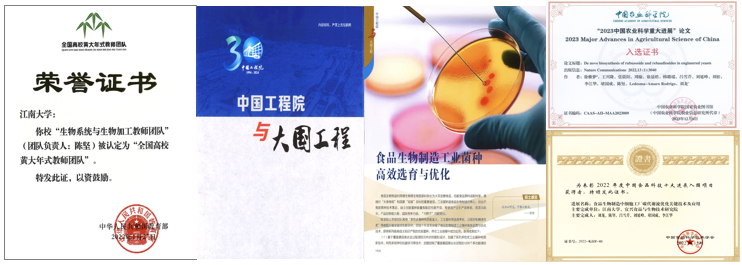

williamhill官网在研究生工程教育领域已有40多年发展历程,目前,在生物与医药专业学位类别招收工程博士研究生,在电子信息、机械、材料与化工、资源与环境、能源动力、土木水利、生物与医药等工程专业学位类别招收工程硕士研究生。
williamhill官网推出“携手江南,追求卓越--四十余载研究生工程教育发展成就巡礼”专题报道,展示各领域工程硕博士培养质量暨卓越工程师产教融合培养典型案例。
本期成就巡礼介绍未来食品科学中心的食品合成生物学与生物制造团队。
以伦世仪院士、陈坚院士为学术带头人的williamhill官网食品合成生物学与生物制造团队始建于1982年,主要从事代谢工程与合成生物学、食品微生物学、生物过程优化与控制、分子及应用酶学等方向的研究。团队由14位教授/研究员、4位副教授/副研究员、4位助理研究员和1位工程师组成。

团队组成
面向国家重大需求,积极践行大食物观。合作企业富祥生物建成年产1200吨镰刀菌蛋白生产线,在亚洲首次实现了丝状真菌微生物蛋白工业化生产,合作企业安琪酵母建成年产万吨酵母蛋白生产线,已于2023年12月获批国家新食品原料。

新质蛋白细胞工厂创制及工业化应用
面向人民生命健康,开发氨糖全生物法制备关键技术。合作企业山东润德生物建成年产1万吨(全球最大)氨糖的生产线,企业获“制造业单项冠军示范企业”和“中国工业大奖表彰奖”,使我国成为全球氨糖生产大国和技术强国。

氨糖全生物法制备关键技术及工业化应用
面向科技前沿与经济主战场,创制系列母乳寡糖(HMOs)细胞工厂。保障关键技术自主可控,其中2′-岩藻糖基乳糖(2′-FL)已在保龄宝建成年产能100吨的工业生产线,后期在建项目全部投产后产能将达到2600吨。

母乳寡糖(HMOs) 细胞工厂及工业化应用
人才培育,桃李蔚起。共培养180余名博士(其中企业在职博士6人)、500余名硕士(其中工程硕士30余人)、大量本科生,目前在读博士90余人中工程博士15人,毕业生广泛分布于高校及科研院所、政府及相关事业机构和国内外企业,60余人成为教授、研究员,其中包括中国工程院院士2名、国家杰出青年基金/国家重大人才工程特聘教授9人次、国家优秀青年基金/国家重大人才工程青年学者获评8人次。
共建平台,产教协契。积极探索建设新型研发机构,为推动产学研用发展搭建研究平台、中试平台和服务平台,与宜兴经济开发区、江苏省产业技术研究院联合共建宜兴食品与生物技术研究院,与嘉兴市秀洲区人民政府、五芳斋集团股份有限公司合作共建嘉兴未来食品研究院。
技术转化,校企联璧。2020年至今共完成技术服务或转让135家公司、签订221份合同、到账经费超2.7亿元,并与茅台集团、青岛啤酒、蒙牛乳业、国信协联、五芳斋、昌进生物、首钢朗泽、富祥药业、华熙生物、天野酶制剂、ADM等国内外知名企业合作建立联合研发中心。

2020年至今服务企业总体情况
科研深耕,硕果盈枝。在Nature Chemical Biology、Nature Synthesis等领域国际权威刊物发表SCI论文500余篇,授权发明专利500余项(其中国际专利60余项),作为第一完成单位获国家技术发明二等奖、国家科技进步二等奖、何梁何利科学与技术创新奖、中国专利金奖和教育部科技进步一等奖等十余项省部级以上奖励。

代表性论文与科技奖励
团队奋进,荣誉累绩。团队先后获得“全国高校黄大年式教师团队”“教育部创新团队”“科技部重点领域创新团队”“江苏省优秀科技创新团队”、江苏省“十佳研究生导师团队”等荣誉,团队成果入选“中国工程院建院30周年100项重大工程科技成果”“2023中国农业科学重大进展”“2022中国食品科技十大进展”“2024中国食品科技十大进展”。
团队其他代表性成果